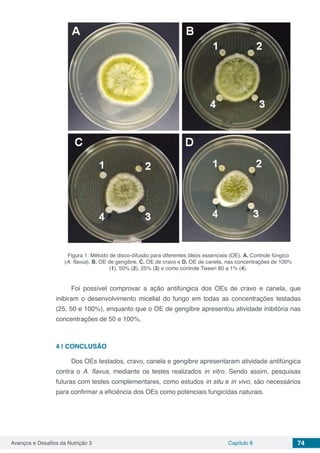
Avanços e Desafios da Nutrição 3 Capítulo 8 74
Figura 1: Método de disco-difusão para diferentes óleos essenciais (OE). A. Controle fúngico
(A. flavus), B. OE de gengibre, C. OE de cravo e D. OE de canela, nas concentrações de 100%
(1), 50% (2), 25% (3) e como controle Tween 80 a 1% (4).
Foi possível comprovar a ação antifúngica dos OEs de cravo e canela, que
inibiram o desenvolvimento micelial do fungo em todas as concentrações testadas
(25, 50 e 100%), enquanto que o OE de gengibre apresentou atividade inibitória nas
concentrações de 50 e 100%.
4 | 	CONCLUSÃO
Dos OEs testados, cravo, canela e gengibre apresentaram atividade antifúngica
contra o A. flavus, mediante os testes realizados in vitro. Sendo assim, pesquisas
futuras com testes complementares, como estudos in situ e in vivo, são necessários
para confirmar a eficiência dos OEs como potenciais fungicidas naturais.

O e-book 'Avanços e Desafios da Nutrição 3' explora a relação multidisciplinar entre nutrição e ciência de alimentos através de 66 artigos científicos. Os temas incluem práticas de manipulação de alimentos, avaliação de compostos bioativos e análise de rotulagem, visando promover reflexões sobre a nutrição e tecnologia de alimentos. A obra é uma contribuição significativa para o entendimento e aperfeiçoamento de práticas alimentares no Brasil.



![Ciências Biológicas e da Saúde
Prof. Dr. Gianfábio Pimentel Franco – Universidade Federal de Santa Maria
Prof. Dr. Benedito Rodrigues da Silva Neto – Universidade Federal de Goiás
Prof.ª Dr.ª Elane Schwinden Prudêncio – Universidade Federal de Santa Catarina
Prof. Dr. José Max Barbosa de Oliveira Junior – Universidade Federal do Oeste do Pará
Profª Drª Natiéli Piovesan – Instituto Federal do Rio Grande do Norte
Profª Drª Raissa Rachel Salustriano da Silva Matos – Universidade Federal do Maranhão
Profª Drª Vanessa Lima Gonçalves – Universidade Estadual de Ponta Grossa
Profª Drª Vanessa Bordin Viera – Universidade Federal de Campina Grande
Ciências Exatas e da Terra e Engenharias
Prof. Dr. Adélio Alcino Sampaio Castro Machado – Universidade do Porto
Prof. Dr. Eloi Rufato Junior – Universidade Tecnológica Federal do Paraná
Prof. Dr. Fabrício Menezes Ramos – Instituto Federal do Pará
Profª Drª Natiéli Piovesan – Instituto Federal do Rio Grande do Norte
Prof. Dr. Takeshy Tachizawa – Faculdade de Campo Limpo Paulista
Conselho Técnico Científico
Prof. Msc. Abrãao Carvalho Nogueira – Universidade Federal do Espírito Santo
Prof.ª Drª Andreza Lopes – Instituto de Pesquisa e Desenvolvimento Acadêmico
Prof. Msc. Carlos Antônio dos Santos – Universidade Federal Rural do Rio de Janeiro
Prof.ª Msc. Jaqueline Oliveira Rezende – Universidade Federal de Uberlândia
Prof. Msc. Leonardo Tullio – Universidade Estadual de Ponta Grossa
Prof. Dr. Welleson Feitosa Gazel – Universidade Paulista
Prof. Msc. André Flávio Gonçalves Silva – Universidade Federal do Maranhão
Prof.ª Msc. Renata Luciane Polsaque Young Blood – UniSecal
Prof. Msc. Daniel da Silva Miranda – Universidade Federal do Pará
Dados Internacionais de Catalogação na Publicação (CIP)
(eDOC BRASIL, Belo Horizonte/MG)
A946 Avanços e desafios da nutrição 3 [recurso eletrônico] /
Organizadoras Vanessa Bordin Viera, Natiéli Piovesan. – Ponta
Grossa, PR: Atena Editora, 2019. – (Avanços e Desafios da
Nutrição no Brasil; v. 3)
Formato: PDF
Requisitos de sistema: Adobe Acrobat Reader
Modo de acesso: World Wide Web
Inclui bibliografia
ISBN 978-85-7247-340-8
DOI 10.22533/at.ed.408192405
1. Nutrição – Pesquisa – Brasil. I. Viera, Vanessa Bordin.
II.Piovesan, Natiéli. III. Série.
CDD 613.2
Elaborado por Maurício Amormino Júnior – CRB6/2422
Atena Editora
Ponta Grossa – Paraná - Brasil
www.atenaeditora.com.br
contato@atenaeditora.com.br](https://image.slidesharecdn.com/e-book-avancos-e-desafios-da-nutricao-191105202808/85/Avancos-e-Desafios-da-Nutricao-3-4-320.jpg)

![Avanços e Desafios da Nutrição 3 Capítulo 12 112
BRASIL. Agência nacional de vigilância sanitária. RDC nº 12, de 02 de janeiro de 2001. A diretoria
colegiada da Agência Nacional de Vigilância Sanitária aprova o regulamento técnico sobre padrões
microbiológicos para alimentos. Diário Oficial [da] República federativa do Brasil, Brasília, 10
de jan. 2001. n. 7, p. 45-53. Disponível em: <http://pesquisa.in.gov.br/imprensa/jsp/visualiza/index.
jsp?data=10/01/2001&jornal=1&pagina=52&totalArquivos=446> Acesso em: 14 de mar. 2013
BRIGHENTI, D. M. et al. Inversão de sacarose utilizando ácido cítrico e suco de limão para
o preparo de dieta energética de Apis mellifera Linnaeus, 1758. Ciência e agrotecnologia,
v. 35, n. 2, p. 297-304, 2011. Disponível em: <http://www.scielo.br/scielo.php?pid=S1413-
70542011000200010&script=sci_abstract&tlng=pt>. Acesso em: 01 de maio 2018.
BUTT, A. A.; ALDRIDGE, K. E.; SANDERS, C. V. Infections related to the ingestion of seafood part I:
viral and bacterial infections. The lancet infectious diseases, v. 4, p. 201-2012, 2004. Disponível em:
<https://www.sciencedirect.com/science/article/pii/S1473309904009697>. Acesso em 22 de jan. 2018.
CAMACHO, S. P. D. et al. Acute outbreak of gnathostomiasis in fishing community in Sinaloa, Mexico.
Parasitology International, v. 52, p. 133-140, 2003. Disponível em: <https://www.sciencedirect.com/
science/article/pii/S1383576903000035>. Acesso em: 20 de fev. 2018.
CASEY, P. G.; CONDON, S. Sodium chloride decreases the bacteriocidal effect of acid pH on
Escherichia coli O157:H45.International journal of food microbiology, v. 76, n. 3, p. 199-206, 2002.
Disponível em: <https://www.sciencedirect.com/science/article/pii/S0168160502000181>. Acesso em:
26 de maio 2018.
CHEVILLE, A. M. et al. spoS regulation of acid, heat, and salt tolerance in Escherichia coli O157:H7.
Applied and environmental microbiology, v. 62, n. 5, p. 1822-1824, 1996. Disponível em: <https://
www.ncbi.nlm.nih.gov/pmc/articles/PMC167958/pdf/621822.pdf>. Acesso em : 23 de maio 2018.
EVANGELISTA-BARRETO, N. S. et al. Moluscos bivalves: organismos bioindicadores da qualidade
microbiológica das águas: uma revisão. Higiene e Sanidade Animal, v. 2, n. 2, p. 18-31, 2008.
Disponível em: <http://www.higieneanimal.ufc.br/seer/index.php/higieneanimal/article/view/38/2058>.
Acesso em 20 de jan. 2018.
FORSYTHE, S. J. Microbiologia da segurança dos alimentos. 2 ed. Porto Alegre: Artmed, 2013,
607 p.
FRANCO, B. D. G. M.; LANDGRAF, M. Microbiologia dos alimentos. São Paulo: Atheneu, 1996. 182
p.
GORDEN, J.; SMALL, P. L. C. Acid resistence in enteric bactéria. Infection and immunity, v. 61,
n. 1, p. 364-367, 1998. Disponível em: <https://www.ncbi.nlm.nih.gov/pmc/articles/PMC302732/pdf/
iai00013-0386.pdf >. Acesso em 16 de maio 2018.
GOSLING, E. Bivalve Molluscs: biology, ecology and Culture. Oxford: Fishing news books, 2003, 443
p.
HERRERA, A. et al. The effect of preparation of cebiche on the survival of enterotoxigenic Escherichia
coli, Aeromonas hydrophila, and Vibrio parahaemolyticus. Travel medicine, v. 17, n. 6, p. 395-399,
2010. Disponível em: <http://onlinelibrary.wiley.com/doi/10.1111/j.1708-8305.2010.00465.x/epdf>.
Acesso em: 20 de fev. 2018.
INSTITUTO ADOLFO LUTZ. Métodos físico-químicos para análise de alimentos. ZENEBON, O.;
PASCUET, N. S.; TIGLEA, P. (coord.), São Paulo: Instituto Adolfo Lutz, 2008.
LOGULLO, R. T. A influência das condições sanitárias sobre a qualidade das águas utilizadas
para a maricultura no Ribeirão da Ilha – Florianópolis, SC. 2005. 155 f. Dissertação (Mestrado em
engenharia ambiental) – Universidade Federal de Santa Catarina, Florianópolis, 2005. Disponível em:
<http://www.tede.ufsc.br/teses/PGEA0217.pdf>. Acesso em: 07 de fev. 2018.](https://image.slidesharecdn.com/e-book-avancos-e-desafios-da-nutricao-191105202808/85/Avancos-e-Desafios-da-Nutricao-3-124-320.jpg)






































![Avanços e Desafios da Nutrição 3 Capítulo 17 151
VIZZOTTO, M.; PEREIRA, E. dos. S.; SCHIAVON, M. V.; FRANZON, R.; BONOW, S. Compostos
Bioativos e Ação Antioxidante de Genótipos Contrastantes de Pêssegos [Prunus persica (L.)
BATSCH]. Boletim de Pesquisa e Desenvolvimento, v. 262, p. 1678-2518, 2017.](https://image.slidesharecdn.com/e-book-avancos-e-desafios-da-nutricao-191105202808/85/Avancos-e-Desafios-da-Nutricao-3-163-320.jpg)






































![Avanços e Desafios da Nutrição 3 Capítulo 21 190
peruviana, como também para outros subprodutos, compostos bioativos e derivados
de alimentos, contribuindo para a ciência de alimentos e a promoção da saúde.
REFERÊNCIAS
ABBASI, F. et al. Ultrasound-assisted preparation of flaxseed oil nanoemulsions coated with
alginate-whey protein for targeted delivery of omega-3 fatty acids into the lower sections of
gastrointestinal tract to enrich broiler meat. Ultrasonics Sonochemistry, v. 50, p. 208-217, 2019.
ABDENNACER, B. et al. Determination of phytochemicals and antioxidant activity of methanol
extracts obtained from the fruit and leaves of Tunisian Lycium intricatum Boiss. Food Chemistry,
v. 174, 577-584, 2015.
ANANDHARAMAKRISHNAN, C. Techniques for Nanoencapsulation of Food Ingredients.
SpringerBriefs in Food, Health, and Nutrition, 2014. 96p.
ARANCIBIA, C. et al. Comparing the effectiveness of natural and synthetic emulsifiers on
oxidative and physical stability of avocado oil-based nanoemulsions. Innovative Food Science &
Emerging Technologies, v. 44, n. Supplement C, p. 159-166, 2017.
BOUCHEMAL, K. et al. Nano-emulsion formulation using spontaneous emulsification: solvent,
oil and surfactant optimisation. International Journal of Pharmaceutics, v. 280, n. 1, p. 241-251,
2004.
BRIGHENTI, A. F. et al. Cultura da Physalis no planalto catarinense e a influência de sistemas de
condução na qualidade dos frutos. In: CONGRESSO BRASILEIRO DE FRUTICULTURA, 20., 2008.
Anais... Vitória: SBF/UFES. CD/ROOM.
BRIONES-LABARCA, V. et al. Extraction of β-Carotene, Vitamin C and Antioxidant Compounds
from Physalis peruviana (Cape Gooseberry) Assisted by High Hydrostatic Pressure. Food and
Nutrition Sciences, v. 4, n.8, p. 109-118, 2013.
CARLI, C.; MORAES-LOVISON, M.; PINHO, S. C. Production, physicochemical stability of
quercetin-loaded nanoemulsions and evaluation of antioxidant activity in spreadable chicken
pâtés. LWT - Food Science and Technology, v. 98, p. 154-161, 2018.
CASTRO, J.; OCAMPO, Y.; FRANCO, L. Cape Gooseberry [Physalis peruviana L.] Calyces
Ameliorate TNBS Acid-induced Colitis in Rats. Journal of Crohn’s and Colitis, v. 9, n. 11, p. 1004-
1015, 2015.
CEDEÑO, M.; MONTENEGRO, D. Plan exportador, logístico y comercialización de uchuva
al mercado de Estados Unidos para FRUTEXPO SCI Ltda. Facultad de Ingeniería, v. Ingeniero
Industrial: Bogotá, Pontificia Universidad Javeriana, 2004.
CONSELHO NACIONAL DO MEIO AMBIENTE. Resolução CONAMA nº 313, de 29 de outubro de
2002. Dispõe sobre o Inventário Nacional de Resíduos Sólidos Industriais. Diário Oficial da União,
Brasília, DF, 22 nov. 2002. Seção 1, p. 85-91. Disponível em <http://www.mma.gov.br/port/conama/
legislacao/CONAMA_RES_CONS_2002_313.pdf>. Acesso em: 27 nov. 2018.
COSTA, N. M. B; ROSA, C. O. B. Alimentos funcionais - componentes bioativos e efeitos
fisiológicos, Cap 1- Alimentos funcionais: Histórico, Legislação e Atributos, 2ª ed. Editora Rubio, Rio
de Janeiro, 2016.
DAG, D.; KILERCIOGLU, M.; OZTOP, M. H. Physical and chemical characteristics of
encapsulated goldenberry (Physalis peruviana L.) juice powder. LWT - Food Science and](https://image.slidesharecdn.com/e-book-avancos-e-desafios-da-nutricao-191105202808/85/Avancos-e-Desafios-da-Nutricao-3-202-320.jpg)




























































































